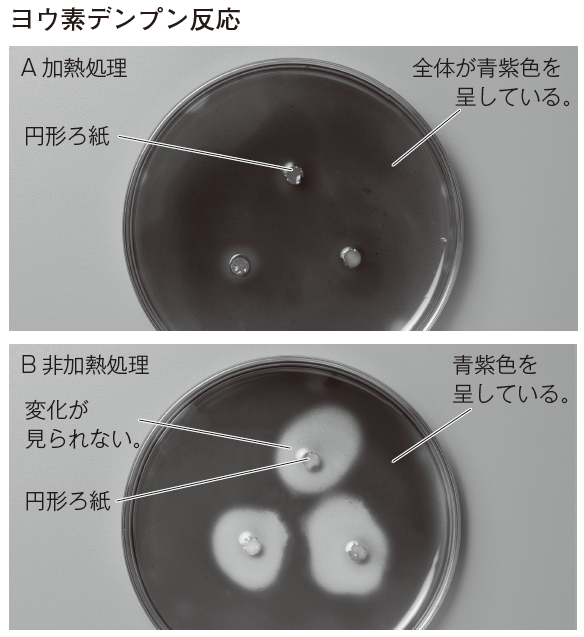

授業のワンポイント
微生物による有機物の分解
■小形の魚が食べたものの観察
教科書p.247の「ためしてみよう」では、小形の魚の胃の内容物を顕微鏡で観察し、何を食べているか調べ、食べる・食べられるの関係を実感させます。
ビーカーにぬるま湯を用意し、カタクチイワシなどの煮干しを5分ほどつけておきます。続いて、胃を取り出して切り開き、内容物をペトリ皿の中に押し出した後、水をスポイトで2~3滴加えます。沈殿物をスポイトで取ってスライドガラスにのせます。カバーガラスからはみ出した余分な水はふき取りましょう。
試料は顕微鏡で100~400倍の倍率で観察します。プランクトンを探すときは100倍、詳しく観察するときには400倍にします。しぼりを用いることを忘れやすいので、観察前に指導しておきましょう。
胃の内容物にはどのようなものがあったかを観察し、この結果から、カタクチイワシのような小形の魚はどのようなものを食べて栄養分を得ているのか、生徒に考察させましょう。
観察に用いるカタクチイワシは、大きな個体のものを選びます。また、背中が反り返っているものは内臓が失われていることが多いので、観察には適していません。

■微生物による有機物の分解
土の中の微生物がデンプンや脱脂粉乳を分解することを、教科書p.255の実験によって確かめます。
使用する土は、運動場などの乾燥したものは避け、林や植えこみ、花壇などから落ち葉の小破片を含む湿ったものを採取します。ビーカーにこの土と水を入れてかき混ぜ、上澄み液を2本の試験管に移します。
円形ろ紙は、作成の際、微生物がつかないように指で触れすぎないようにします。あらかじめ用意しておき、密閉できる容器に、班ごとの分を保存しておくとよいでしょう。
一方の試験管はガスバーナーで加熱して沸騰させ、もう一方の試験管はそのままで、前者の上澄み液に浸した円形ろ紙をA、後者の上澄み液に浸した円形ろ紙をBとします。
そして、2つの寒天培地の上に、それぞれ、ろ紙AとBを置き、ふたをします。2~4日後にろ紙の周りにおける色の変化を観察します。ろ紙を置く際、寒天培地の汚染に注意させ、用いるピンセットを使い分ける工夫をしてもよいでしょう。
結果は次の写真のように観察されます。この色の変化が何を意味するのか、生徒に考察させましょう。

<寒天培地>
①ペトリ皿とふたを熱湯殺菌する。
②水100mLあたり、寒天2.5g、可溶性デンプン1g、脱脂粉乳1gを加えてつくった溶液を大きめのビーカーに入れ、弱火で加熱する。
③ふきこぼれないようにかき混ぜ、沸騰したら火を止め、厚さ5mmを目安にペトリ皿に注ぐ。
④その後ふたをして、自然に固まるまで室温で放置する。
なお、この実験では、実験結果が出るまで数日を要します。時間が無いときは、寒天培地にろ紙を置くところまでは、事前に教員側で行うなど、柔軟に変更するとよいでしょう。
[環境]自然と人間
1章 自然界のつり合い
(教科書p.244~259)
アンケート
よろしければ記事についてのご意見をお聞かせください。
Q1またはQ3のいずれか一方はご入力ください。

